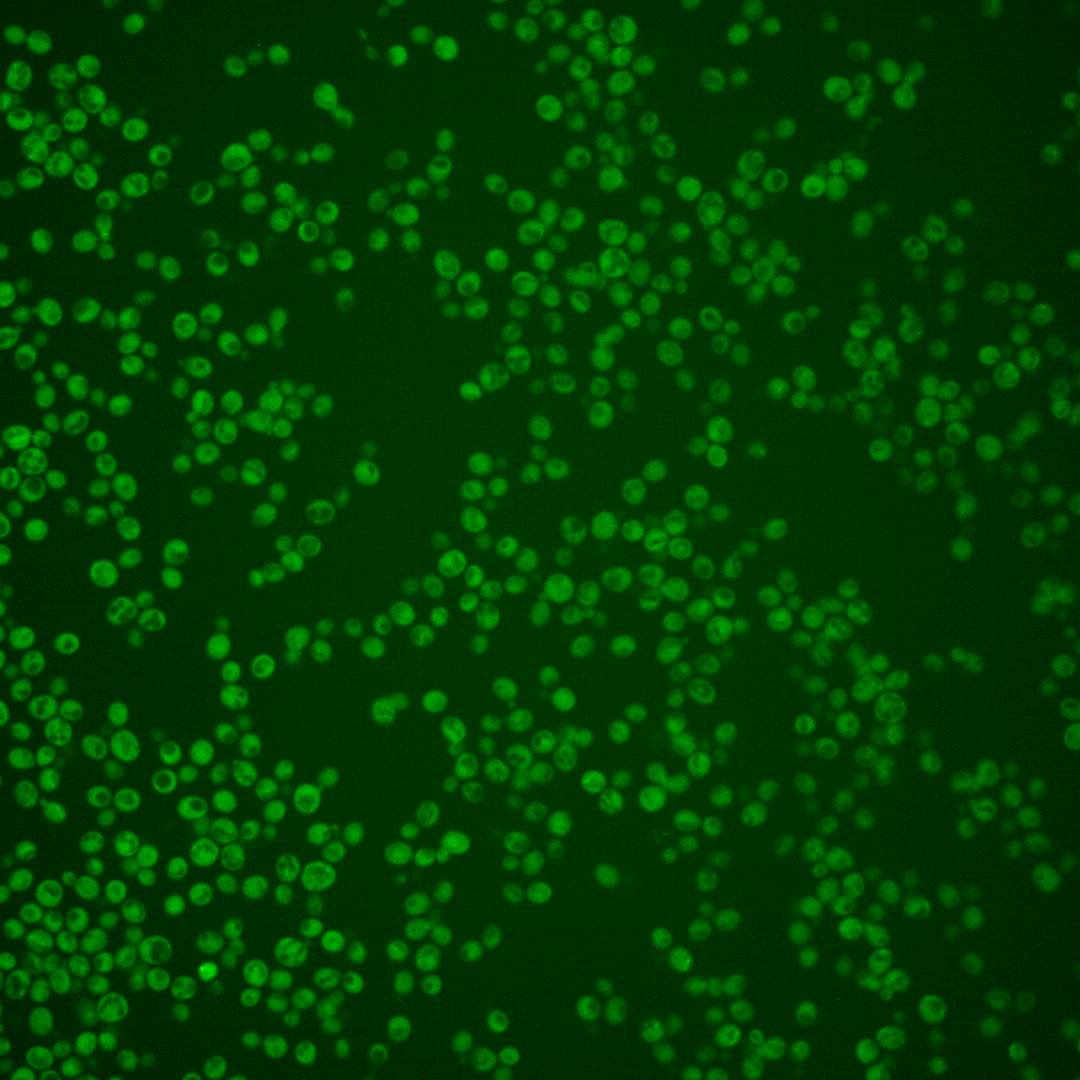
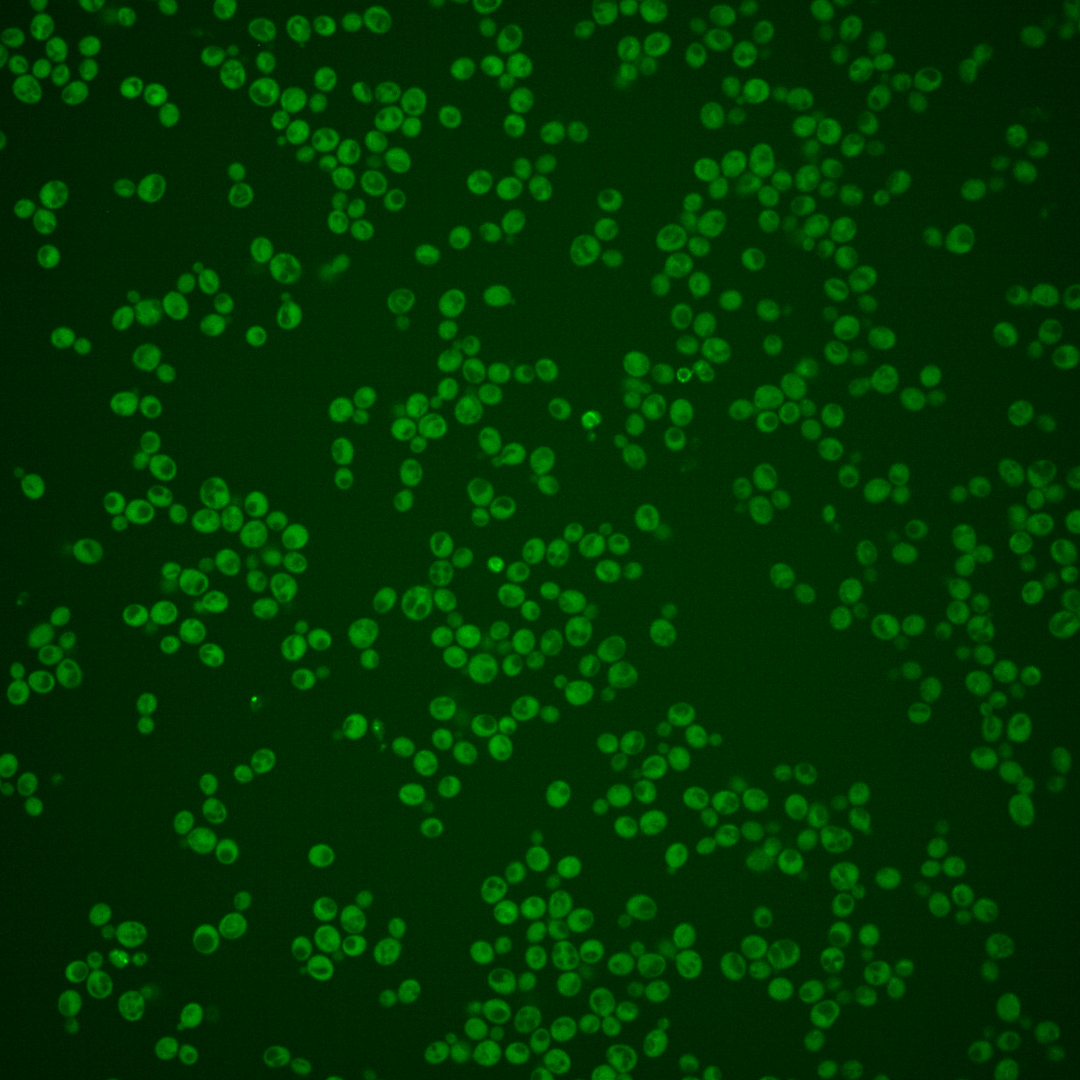
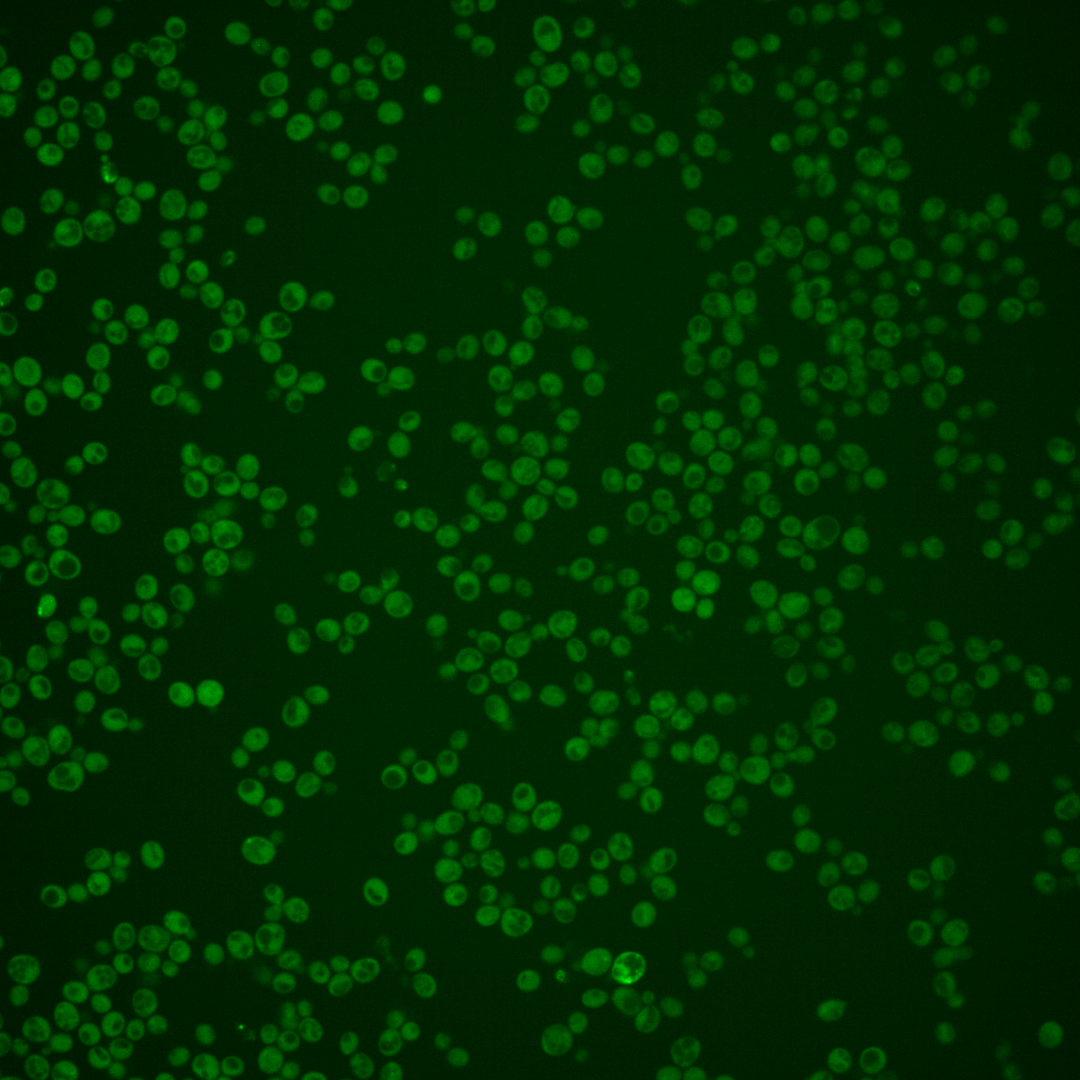
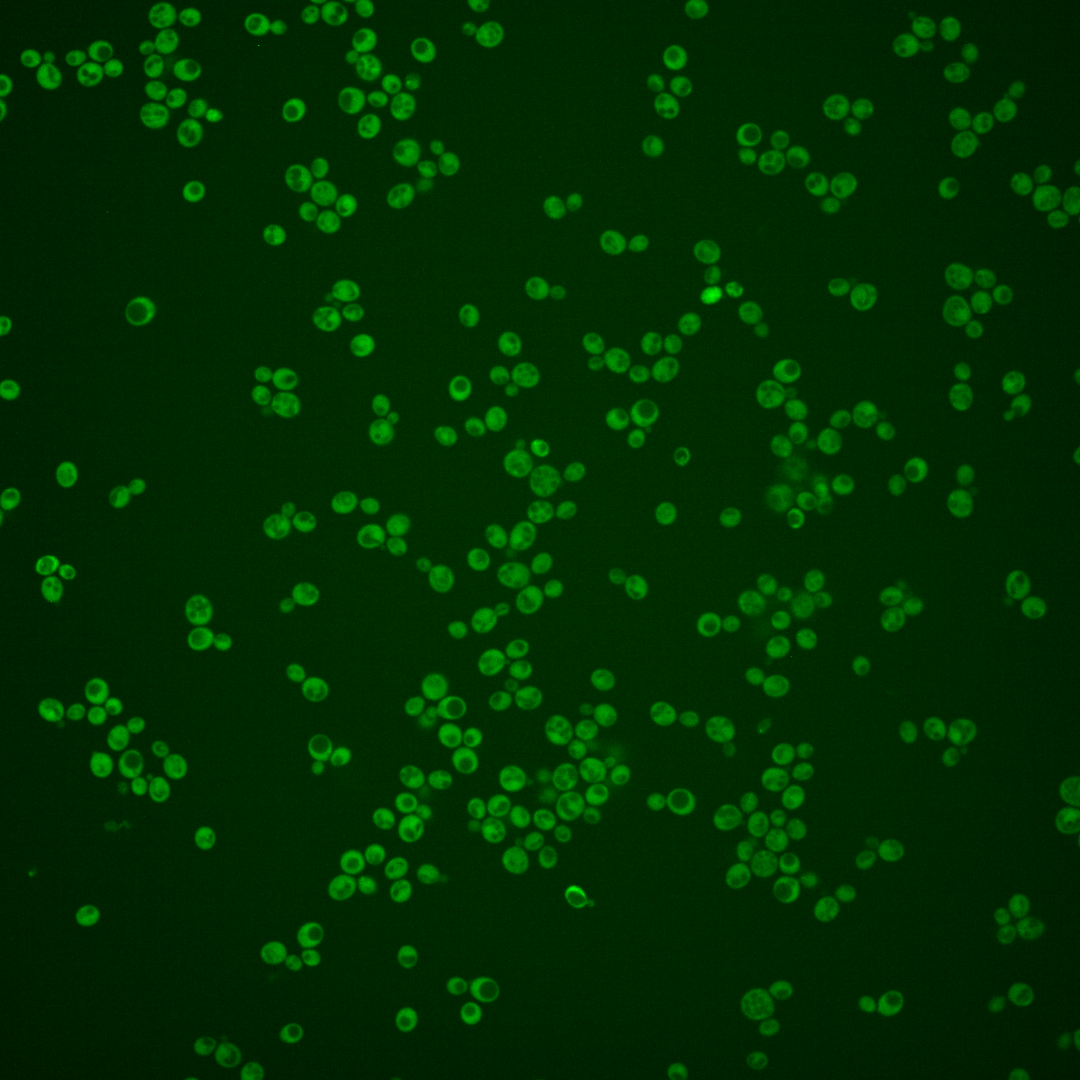
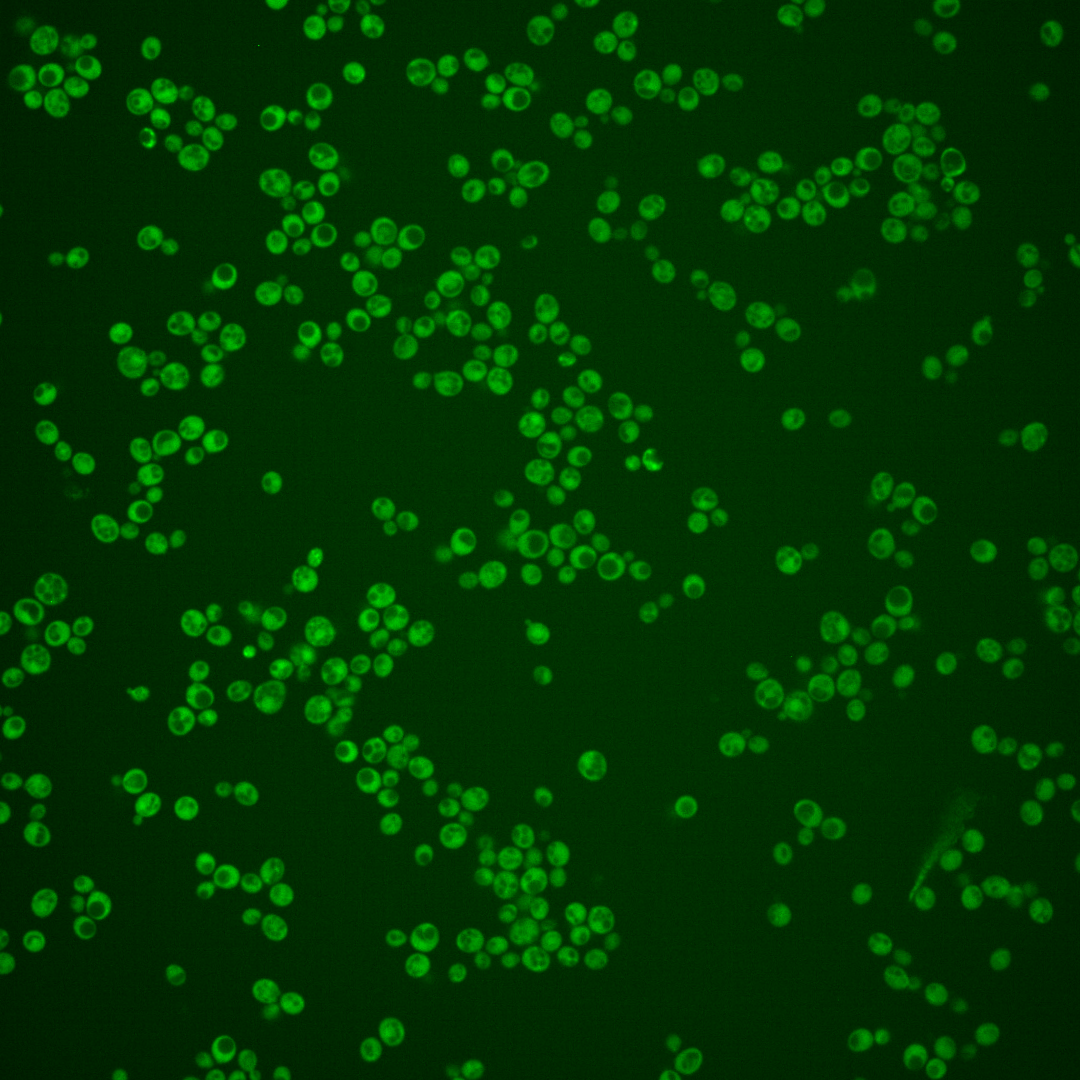
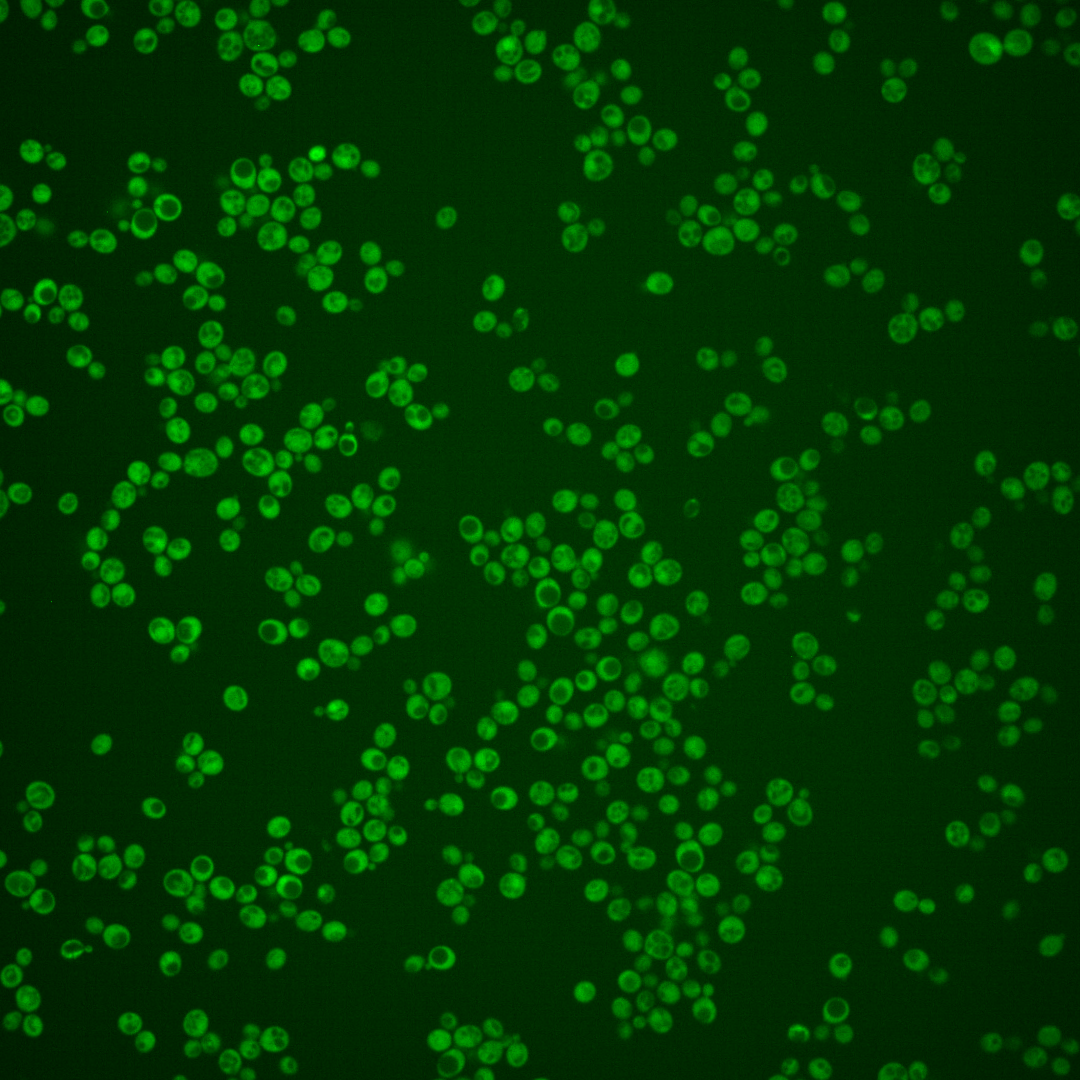

| Standard name | |
|---|---|
| Human Ortholog | |
| Description | Phosphotyrosine-specific protein phosphatase; major role in the pheromone adaptive response through dephosphorylation of the Fus3p MAPK with a minor role by Ptp2p and Msg5p; minor role in the inactivation of Hog1p MAPK during osmolarity sensing with major role by Ptp2p; dephosphorylates and regulates the localization of Hog1p; minor role in the cell wall integrity pathway through tyrosine dephosphorylation of the MAPK Slt2p while Ptp2p plays a major role; localizes to the cytoplasm |
Micrographs




















































































Sub-cellular Localization
Yeast GFP Assignment
Protein Abundance
Localization Change
External localization resources
| ensLOC | DeepLoc | |||||||||||||||||||||||
|---|---|---|---|---|---|---|---|---|---|---|---|---|---|---|---|---|---|---|---|---|---|---|---|---|
| Localization | WT1 | WT2 | WT3 | RAP60 | RAP140 | RAP220 | RAP300 | RAP380 | RAP460 | RAP540 | RAP620 | RAP700 | HU80 | HU120 | HU160 | rpd3Δ_1 | rpd3Δ_2 | rpd3Δ_3 | WT1 | WT2 | WT3 | AF100 | AF140 | AF180 |
| Cortical Patches | 0 | 0 | 0 | 0 | 0 | 0 | 0 | 0 | 0 | – | 0 | 0 | 0 | 0 | 0 | 0 | 2 | 0 | 1 | 1 | 0 | 0 | 0 | 0 |
| Bud | 1 | 0 | 1 | 0 | 1 | 4 | 4 | 7 | 10 | – | 5 | 2 | 1 | 5 | 6 | 0 | 0 | 0 | 0 | 1 | 0 | 0 | 1 | 5 |
| Bud Neck | 0 | 0 | 0 | 0 | 1 | 0 | 1 | 4 | 2 | – | 0 | 1 | 0 | 0 | 0 | 0 | 0 | 0 | 1 | 1 | 0 | 2 | 0 | 2 |
| Bud Site | 0 | 0 | 0 | 0 | 0 | 0 | 1 | 0 | 2 | – | 0 | 0 | 0 | 0 | 0 | 0 | 0 | 0 | – | – | – | – | – | – |
| Cell Periphery | 8 | 0 | 0 | 1 | 0 | 0 | 4 | 5 | 1 | – | 3 | 5 | 3 | 5 | 9 | 12 | 13 | 15 | 0 | 0 | 0 | 0 | 0 | 0 |
| Cytoplasm | 289 | 22 | 113 | 256 | 287 | 287 | 427 | 475 | 296 | – | 129 | 210 | 197 | 460 | 472 | 433 | 256 | 470 | 286 | 39 | 109 | 168 | 274 | 356 |
| Endoplasmic Reticulum | 2 | 0 | 3 | 0 | 1 | 0 | 0 | 0 | 0 | – | 0 | 2 | 1 | 0 | 0 | 21 | 13 | 26 | 1 | 1 | 2 | 0 | 2 | 7 |
| Endosome | 0 | 0 | 0 | 0 | 1 | 0 | 0 | 4 | 0 | – | 0 | 0 | 0 | 0 | 1 | 3 | 3 | 3 | 1 | 0 | 0 | 0 | 1 | 4 |
| Golgi | 0 | 0 | 0 | 0 | 0 | 0 | 0 | 0 | 0 | – | 0 | 0 | 0 | 0 | 0 | 0 | 0 | 1 | 1 | 0 | 0 | 0 | 0 | 0 |
| Mitochondria | 2 | 7 | 16 | 24 | 14 | 52 | 85 | 112 | 134 | – | 71 | 141 | 0 | 6 | 25 | 11 | 2 | 7 | 1 | 1 | 7 | 1 | 5 | 7 |
| Nucleus | 1 | 0 | 0 | 2 | 0 | 1 | 1 | 3 | 1 | – | 0 | 0 | 0 | 0 | 0 | 5 | 0 | 3 | 0 | 0 | 0 | 1 | 0 | 0 |
| Nuclear Periphery | 0 | 0 | 0 | 0 | 0 | 0 | 0 | 0 | 0 | – | 0 | 1 | 0 | 0 | 0 | 0 | 0 | 1 | 0 | 0 | 0 | 0 | 0 | 1 |
| Nucleolus | 0 | 0 | 0 | 0 | 0 | 0 | 0 | 1 | 0 | – | 0 | 0 | 0 | 1 | 1 | 0 | 0 | 0 | 0 | 0 | 0 | 0 | 0 | 0 |
| Peroxisomes | 0 | 0 | 0 | 0 | 0 | 0 | 0 | 0 | 0 | – | 0 | 0 | 0 | 0 | 0 | 0 | 0 | 0 | 1 | 0 | 0 | 0 | 0 | 0 |
| SpindlePole | 0 | 0 | 0 | 0 | 0 | 2 | 6 | 4 | 1 | – | 4 | 5 | 0 | 0 | 0 | 0 | 0 | 1 | 0 | 0 | 0 | 0 | 1 | 1 |
| Vac/Vac Membrane | 1 | 0 | 1 | 0 | 1 | 0 | 0 | 1 | 2 | – | 0 | 0 | 0 | 1 | 0 | 11 | 3 | 11 | 0 | 0 | 5 | 4 | 4 | 7 |
| Unique Cell Count | 295 | 24 | 120 | 261 | 293 | 297 | 451 | 522 | 344 | 162 | 283 | 198 | 467 | 478 | 446 | 263 | 481 | 299 | 50 | 130 | 183 | 298 | 401 | |
| Labelled Cell Count | 304 | 29 | 134 | 283 | 306 | 346 | 529 | 616 | 449 | 212 | 367 | 202 | 478 | 514 | 496 | 292 | 538 | 299 | 50 | 130 | 183 | 298 | 401 | |
Yeast GFP Assignment
Protein Abundance
| Screen | WT1 | WT2 | WT3 | RAP60 | RAP140 | RAP220 | RAP300 | RAP380 | RAP460 | RAP540 | RAP620 | RAP700 | HU80 | HU120 | HU160 | rpd3Δ_1 | rpd3Δ_2 | rpd3Δ_3 | AF100 | AF140 | AF180 |
|---|---|---|---|---|---|---|---|---|---|---|---|---|---|---|---|---|---|---|---|---|---|
| Mean Cell GFP Intensity (1e-4) | 5.8 | 4.6 | 3.7 | 3.9 | 4.0 | 3.3 | 3.0 | 3.3 | 2.7 | – | 2.7 | 2.4 | 5.8 | 5.7 | 4.7 | 6.2 | 6.6 | 6.8 | 5.6 | 5.3 | 5.2 |
| Std Deviation (1e-4) | 0.5 | 0.7 | 0.6 | 1.1 | 1.6 | 1.2 | 1.1 | 1.7 | 1.0 | – | 0.7 | 0.5 | 1.1 | 1.1 | 0.9 | 0.9 | 1.2 | 1.1 | 1.2 | 1.0 | 1.4 |
| Intensity Change (Log2) | – | – | – | 0.08 | 0.11 | -0.15 | -0.28 | -0.13 | -0.46 | – | -0.44 | -0.62 | 0.66 | 0.64 | 0.37 | 0.77 | 0.86 | 0.9 | 0.62 | 0.52 | 0.5 |
Localization Change
| Localization | RAP60 | RAP140 | RAP220 | RAP300 | RAP380 | RAP460 | RAP540 | RAP620 | RAP700 | HU80 | HU120 | HU160 | rpd3Δ_1 | rpd3Δ_2 | rpd3Δ_3 |
|---|---|---|---|---|---|---|---|---|---|---|---|---|---|---|---|
| Actin | – | – | – | – | – | – | – | – | – | – | – | – | – | – | – |
| Bud | – | – | – | – | – | – | – | – | – | – | – | – | – | – | – |
| Bud Neck | – | – | – | – | – | – | – | – | – | – | – | – | – | – | – |
| Bud Site | – | – | – | – | – | – | – | – | – | – | – | – | – | – | – |
| Cell Periphery | – | – | – | – | – | – | – | – | – | – | – | – | – | – | – |
| Cyto | – | – | – | – | – | – | – | – | – | – | – | – | – | – | – |
| Endoplasmic Reticulum | – | – | – | – | – | – | – | – | – | – | – | – | – | – | – |
| Endosome | – | – | – | – | – | – | – | – | – | – | – | – | – | – | – |
| Golgi | – | – | – | – | – | – | – | – | – | – | – | – | – | – | – |
| Mitochondria | – | – | – | – | – | – | – | – | – | – | – | – | – | – | – |
| Nuclear Periphery | – | – | – | – | – | – | – | – | – | – | – | – | – | – | – |
| Nuc | – | – | – | – | – | – | – | – | – | – | – | – | – | – | – |
| Nucleolus | – | – | – | – | – | – | – | – | – | – | – | – | – | – | – |
| Peroxisomes | – | – | – | – | – | – | – | – | – | – | – | – | – | – | – |
| SpindlePole | – | – | – | – | – | – | – | – | – | – | – | – | – | – | – |
| Vac | – | – | – | – | – | – | – | – | – | – | – | – | – | – | – |
| Cortical Patches | – | – | – | – | – | – | – | – | – | – | – | – | – | – | – |
| Cytoplasm | – | – | – | – | – | – | – | – | – | – | – | – | – | – | – |
| Nucleus | – | – | – | – | – | – | – | – | – | – | – | – | – | – | – |
| Vacuole | – | – | – | – | – | – | – | – | – | – | – | – | – | – | – |
External localization resources
Images






























Protein Concentration and Protein Localization Data
| R1 | R2 | R3 | ||||||||||||||||
|---|---|---|---|---|---|---|---|---|---|---|---|---|---|---|---|---|---|---|
| G1 Pre-START | G1 Post-START | S/G2 | Metaphase | Anaphase | Telophase | G1 Pre-START | G1 Post-START | S/G2 | Metaphase | Anaphase | Telophase | G1 Pre-START | G1 Post-START | S/G2 | Metaphase | Anaphase | Telophase | |
| Concentration | 2.2898 | 2.6092 | 2.4114 | 2.2783 | 2.0635 | 2.6636 | 2.1873 | 3.1997 | 2.9507 | 2.6001 | 2.9084 | 2.9776 | 0.9031 | 1.3563 | 1.0408 | 0.8077 | 0.9597 | 1.3177 |
| Actin | 0.0126 | 0.0003 | 0.0131 | 0.0008 | 0.0239 | 0.0193 | 0.0079 | 0.0028 | 0.0073 | 0.0003 | 0.0059 | 0.0023 | 0.04 | 0.0002 | 0.0083 | 0.0002 | 0.0005 | 0.0077 |
| Bud | 0.0017 | 0.0008 | 0.0045 | 0.0057 | 0.0022 | 0.0049 | 0.0007 | 0.0009 | 0.0031 | 0.0002 | 0.0006 | 0.0004 | 0.0005 | 0.0002 | 0.0031 | 0.0003 | 0.0002 | 0.0021 |
| Bud Neck | 0.0064 | 0.0003 | 0.0006 | 0.0008 | 0.0029 | 0.008 | 0.0005 | 0.0002 | 0.0003 | 0.0012 | 0.0004 | 0.0008 | 0.003 | 0.0002 | 0.0006 | 0.0003 | 0.0003 | 0.0022 |
| Bud Periphery | 0.0028 | 0.0007 | 0.007 | 0.0092 | 0.0082 | 0.0057 | 0.0009 | 0.0008 | 0.004 | 0.0001 | 0.0007 | 0.0005 | 0.0009 | 0.0002 | 0.0036 | 0.0002 | 0.0003 | 0.0037 |
| Bud Site | 0.0047 | 0.009 | 0.0027 | 0.0027 | 0.0059 | 0.004 | 0.0018 | 0.0074 | 0.0033 | 0.0012 | 0.0014 | 0.0002 | 0.0034 | 0.0012 | 0.0156 | 0.0004 | 0.0004 | 0.0021 |
| Cell Periphery | 0.0025 | 0.0015 | 0.0009 | 0.0013 | 0.0012 | 0.0009 | 0.0004 | 0.0003 | 0.0002 | 0 | 0.0001 | 0 | 0.0005 | 0.0003 | 0.0009 | 0.0001 | 0.0002 | 0.0003 |
| Cytoplasm | 0.6869 | 0.8097 | 0.7858 | 0.8174 | 0.7714 | 0.8346 | 0.7295 | 0.856 | 0.7966 | 0.925 | 0.7014 | 0.8743 | 0.5838 | 0.8246 | 0.7231 | 0.7862 | 0.6799 | 0.7199 |
| Cytoplasmic Foci | 0.0216 | 0.0065 | 0.0157 | 0.0163 | 0.0254 | 0.0159 | 0.0115 | 0.0089 | 0.0149 | 0.0228 | 0.0299 | 0.0135 | 0.0248 | 0.0067 | 0.0185 | 0.0107 | 0.0152 | 0.0164 |
| Eisosomes | 0.0002 | 0.0001 | 0.0001 | 0.0001 | 0.0004 | 0.0001 | 0.0001 | 0 | 0 | 0 | 0 | 0 | 0.0005 | 0 | 0.0003 | 0 | 0.0001 | 0.0001 |
| Endoplasmic Reticulum | 0.0082 | 0.0092 | 0.0052 | 0.0035 | 0.0022 | 0.0044 | 0.0147 | 0.0017 | 0.0018 | 0.0012 | 0.0025 | 0.0031 | 0.0076 | 0.0013 | 0.0043 | 0.0016 | 0.0029 | 0.0024 |
| Endosome | 0.0303 | 0.0042 | 0.0246 | 0.0135 | 0.0226 | 0.0086 | 0.0258 | 0.0058 | 0.0117 | 0.0086 | 0.0498 | 0.0112 | 0.0239 | 0.0035 | 0.013 | 0.0074 | 0.0202 | 0.0086 |
| Golgi | 0.0072 | 0.0004 | 0.0094 | 0.0006 | 0.0122 | 0.0037 | 0.0061 | 0.0016 | 0.0089 | 0.0008 | 0.0239 | 0.0061 | 0.0091 | 0.0003 | 0.0034 | 0.0003 | 0.0019 | 0.0014 |
| Lipid Particles | 0.0115 | 0.0003 | 0.0052 | 0.0009 | 0.011 | 0.0014 | 0.0014 | 0.0003 | 0.0023 | 0.0002 | 0.0428 | 0.0036 | 0.012 | 0.0001 | 0.0049 | 0.0001 | 0.0026 | 0.0013 |
| Mitochondria | 0.0236 | 0.0003 | 0.0041 | 0.0009 | 0.0225 | 0.0013 | 0.0031 | 0.0008 | 0.0232 | 0.0002 | 0.0359 | 0.0063 | 0.0107 | 0.0001 | 0.0027 | 0.0002 | 0.0052 | 0.0008 |
| None | 0.1546 | 0.1498 | 0.1067 | 0.1117 | 0.0662 | 0.0801 | 0.1635 | 0.1044 | 0.1071 | 0.0341 | 0.0844 | 0.06 | 0.2532 | 0.1584 | 0.1866 | 0.187 | 0.259 | 0.2264 |
| Nuclear Periphery | 0.0022 | 0.0007 | 0.0019 | 0.001 | 0.001 | 0.0009 | 0.0104 | 0.0011 | 0.0006 | 0.0003 | 0.0015 | 0.005 | 0.0028 | 0.0003 | 0.0011 | 0.0004 | 0.001 | 0.0004 |
| Nucleolus | 0.0005 | 0.0002 | 0.0002 | 0.0004 | 0.0011 | 0.0001 | 0.0003 | 0.0006 | 0.0001 | 0 | 0.0002 | 0.0001 | 0.0011 | 0 | 0.0002 | 0.0001 | 0.0008 | 0.0001 |
| Nucleus | 0.0027 | 0.0013 | 0.0015 | 0.0018 | 0.0027 | 0.0011 | 0.0034 | 0.002 | 0.0007 | 0.0007 | 0.0008 | 0.0032 | 0.0017 | 0.0005 | 0.0013 | 0.0008 | 0.0016 | 0.0005 |
| Peroxisomes | 0.0089 | 0 | 0.0021 | 0.0002 | 0.0096 | 0.0014 | 0.0004 | 0.0005 | 0.0081 | 0.0002 | 0.0108 | 0.0071 | 0.0082 | 0 | 0.0029 | 0.0001 | 0.0027 | 0.0017 |
| Punctate Nuclear | 0.0012 | 0.0004 | 0.0008 | 0.0009 | 0.003 | 0.0004 | 0.0101 | 0.0006 | 0.0002 | 0.0005 | 0.0028 | 0.0004 | 0.006 | 0.0001 | 0.0011 | 0.0002 | 0.0022 | 0.0007 |
| Vacuole | 0.0086 | 0.004 | 0.0067 | 0.0094 | 0.0036 | 0.0027 | 0.0063 | 0.0026 | 0.0041 | 0.002 | 0.0027 | 0.0013 | 0.0055 | 0.0016 | 0.0039 | 0.0032 | 0.0023 | 0.001 |
| Vacuole Periphery | 0.0013 | 0.0003 | 0.0011 | 0.0009 | 0.0009 | 0.0005 | 0.0014 | 0.0006 | 0.0014 | 0.0004 | 0.0015 | 0.0005 | 0.0008 | 0.0002 | 0.0006 | 0.0004 | 0.0006 | 0.0002 |
Sequencing Data
| R1 | R2 | |||||||||
|---|---|---|---|---|---|---|---|---|---|---|
| G1 Post-START | S/G2 | Metaphase | Anaphase | Telophase | G1 Post-START | S/G2 | Metaphase | Anaphase | Telophase | |
| Gene Expression | 12.8671 | 8.4941 | 5.5151 | 10.6707 | 8.2131 | 7.5181 | 11.0933 | 11.1101 | 9.7077 | 13.5764 |
| Translational Efficiency | 0.3642 | 0.6878 | 0.7886 | 0.4045 | 0.6247 | 0.7669 | 0.5503 | 0.4209 | 0.5465 | 0.5041 |
Hit Data
| Dataset | Hit |
|---|---|
| Protein Concentration | ✘ |
| Protein Localization | ✘ |
| Gene Expression | ✘ |
| Translational Efficiency | ✘ |
Endocytosis
| Temp | Actin Patch (Sac6-tdTomato) | Cortical Patch (Sla1-GFP) | Late Endosome (Snf7-GFP) | Vacuole (Vph1-GFP) |
|---|---|---|---|---|
| 37℃ | ||||
| RT |
Cell Cycle Omics
CYCLoPs (Ptp3-GFP)
| Gene / Allele | Actin Patch (Sac6-tdTomato) | Cortical Patch (Sla1-GFP) | Late Endosome (Snf7-GFP) | Vacuole (Sac6-tdTomato) |
|---|
| Gene | Images |
|---|
| Gene | Images |
|---|
Images are not yet available
Images are not yet available